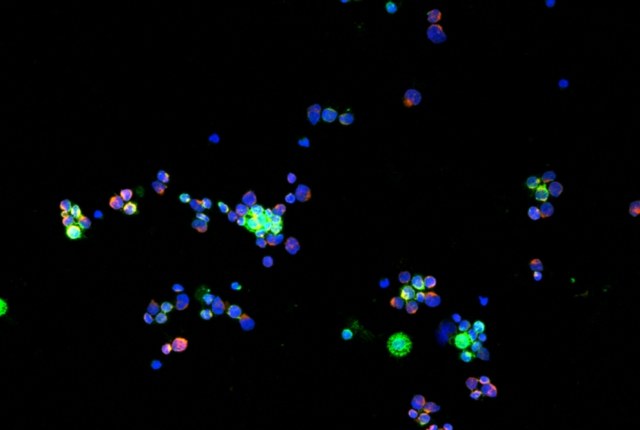

Tumori ematologici e CAR-T: nel nanomondo i messaggi cellulari che predicono il futuro
Un terzo dei pazienti che ricevono terapie cellulari avanzate sviluppa come effetto collaterale una seria sindrome da neurotossicità: un nuovo studio scientifico svela come individuare questa complicazione con giorni di anticipo, consentendo ai medici di trattarla efficacemente
Sessanta minuti. È sufficiente attendere appena un’ora, dal momento dell’infusione delle CAR-T, per capire se il paziente rischia di sviluppare neurotossicità nei giorni successivi. E il merito di questa novità va attribuito a strutture biologiche grandi appena 100 nanometri: le vescicole extracellulari.
È quanto emerge da uno studio guidato da ricercatori dell'IRCCS Policlinico di Sant’Orsola e dell'Università di Bologna, pubblicato sul "Journal of Clinical Investigation". Gli studiosi hanno scoperto un metodo per prevedere con diversi giorni d’anticipo la probabile insorgenza dell’ICANS, la sindrome da neurotossicità associata a terapia con cellule immunoeffettrici.
Questa sindrome è un effetto collaterale che interessa circa un terzo dei pazienti oncoematologici trattati con CAR-T: una terapia cellulare avanzata che utilizza i linfociti-T (quindi cellule del sistema immunitario) dello stesso paziente per combattere i tumori ematologici, come i linfomi o i mielomi.
L'ICANS si manifesta a 5-7 giorni di distanza dall’infusione sotto forma di confusione, disturbo del linguaggio, disturbo motorio e convulsioni. Nei casi più gravi può portare al coma o al decesso, motivo per cui rappresenta una delle complicazioni più temute della terapia cellulare.
Il nuovo studio ha dimostrato che un’alta concentrazione di vescicole extracellulari nel sangue, misurata ad un’ora di distanza dall’infusione della terapia cellulare, si correla fortemente allo sviluppo di ICANS entro la settimana successiva.
Conoscere in anticipo il probabile sviluppo di questa complicanza consente non solo di modulare per tempo la risposta terapeutica, ma anche di accorciare i tempi di degenza. Al momento, infatti, i pazienti restano ricoverati per circa due settimane a scopo precauzionale: grazie a questa novità, i casi ritenuti non a rischio potranno invece essere dimessi in sicurezza.
"Si tratta di un risultato eccezionale, un ulteriore passo in avanti per una terapia che rappresenta una delle frontiere più innovative e promettenti nella lotta a mielomi e linfomi", spiega Francesca Bonifazi, direttrice della Piattaforma di Immunobiologia dei trapianti e delle terapie cellulari e dell’unità operativa complessa Trapianto e Terapie Cellulari in Ematologia dell’IRCCS. "Questo studio ha non soltanto un grande valore dal punto di vista clinico, ma anche sul fronte della ricerca: è un grande passo in avanti nella comprensione della patogenesi della complicanza".
Le vescicole extracellulari sono strutture biologiche prodotte da tutte le cellule del corpo umano e negli ultimi anni sono state identificate come agenti universali della comunicazione intercellulare e inter-organismica. In sostanza, possono essere descritte come una sorta di nano-navette che le cellule utilizzano per scambiarsi informazioni. Ciascuna vescicola contiene infatti una proteina della cellula di origine e si muove fino alla sua destinazione attraverso i liquidi extracellulari come il plasma sanguigno.
Le vescicole possano spostarsi all’interno del corpo umano coprendo anche grandi distanze rispetto alla cellula di origine: ciò le rende delle candidate ideali per studiare quello che avviene all’interno di un tessuto che altrimenti non potrebbe essere studiato (o che potrebbe essere studiato solo tramite tecniche invasive).
"Nel corso della nostra ricerca abbiamo scoperto che la maggior parte delle vescicole extracellulari di una CAR-T viene prodotta quando questa cellula incontra il suo bersaglio, la cellula tumorale", spiega Massimiliano Bonafè, professore di Patologia Generale al Dipartimento di Scienze Mediche e Chirurgiche dell’Università di Bologna e referente scientifico del laboratorio in cui sono stati condotti gli esperimenti. "A quel punto ci siamo chiesti: la quantità di vescicole ha un ruolo nello sviluppo dell’ICANS? In altre parole: il valore che rileviamo è predittivo nei confronti di una complicanza che si manifesta nei giorni successivi?"
In entrambi i casi, la risposta si è rivelata affermativa. Lo studio è stato condotto su una coorte di 100 pazienti trattati con terapia CAR-T per linfoma a cellule B e seguiti dal programma dipartimentale di Diagnosi e terapie dei linfomi e delle sindromi linfoproliferative croniche dell’IRCCS Policlinico di Sant’Orsola, diretto da Pier Luigi Zinzani, professore ordinario di Ematologia all'Alma Mater e direttore della unità operativa complessa Ematologia dell’IRCCS AOU. I risultati mostrano che alti livelli di queste vescicole si correlano ad un’alta possibilità di sviluppare la neurotossicità.
Non solo. La ricerca, avvalendosi della collaborazione di Spartaco Santi, ricercatore dell’Istituto di Genetica Molecolare del CNR di Bologna, ha anche riprodotto in vitro un modello neuronale per comprendere come l’aumento della produzione di vescicole determina lo sviluppo della sindrome.
"Abbiamo scoperto che le vescicole, quando incontrano i neuroni del sistema nervoso centrale, non li uccidono (e quindi non sono tossiche) ma li stressano", aggiunge Massimiliano Bonafè. "Questa reazione da stress, poi, può essere misurata attraverso altre vescicole prodotte dai neuroni".
Lo studio rappresenta un grande risultato per la Piattaforma di Immunobiologia dei trapianti e delle terapie cellulari, nata nel 2022 per mettere in rete le risorse e le competenze dei ricercatori dell’IRCCS Policlinico di Sant’Orsola e dell’Università di Bologna e divenuta ben presto un modello da imitare.
"Siamo una quindicina tra biologi ed ematologi – conclude Francesca Bonifazi – afferenti a IRCCS Policlinico di Sant’Orsola o all’Università di Bologna, per ottenere grandi risultati è necessario un lavoro di squadra. E questo studio lo conferma: le prime due firme sono di un ricercatore sanitario IRCCS e di un dottorando UNIBO, Gianluca Storci e Francesco De Felice".